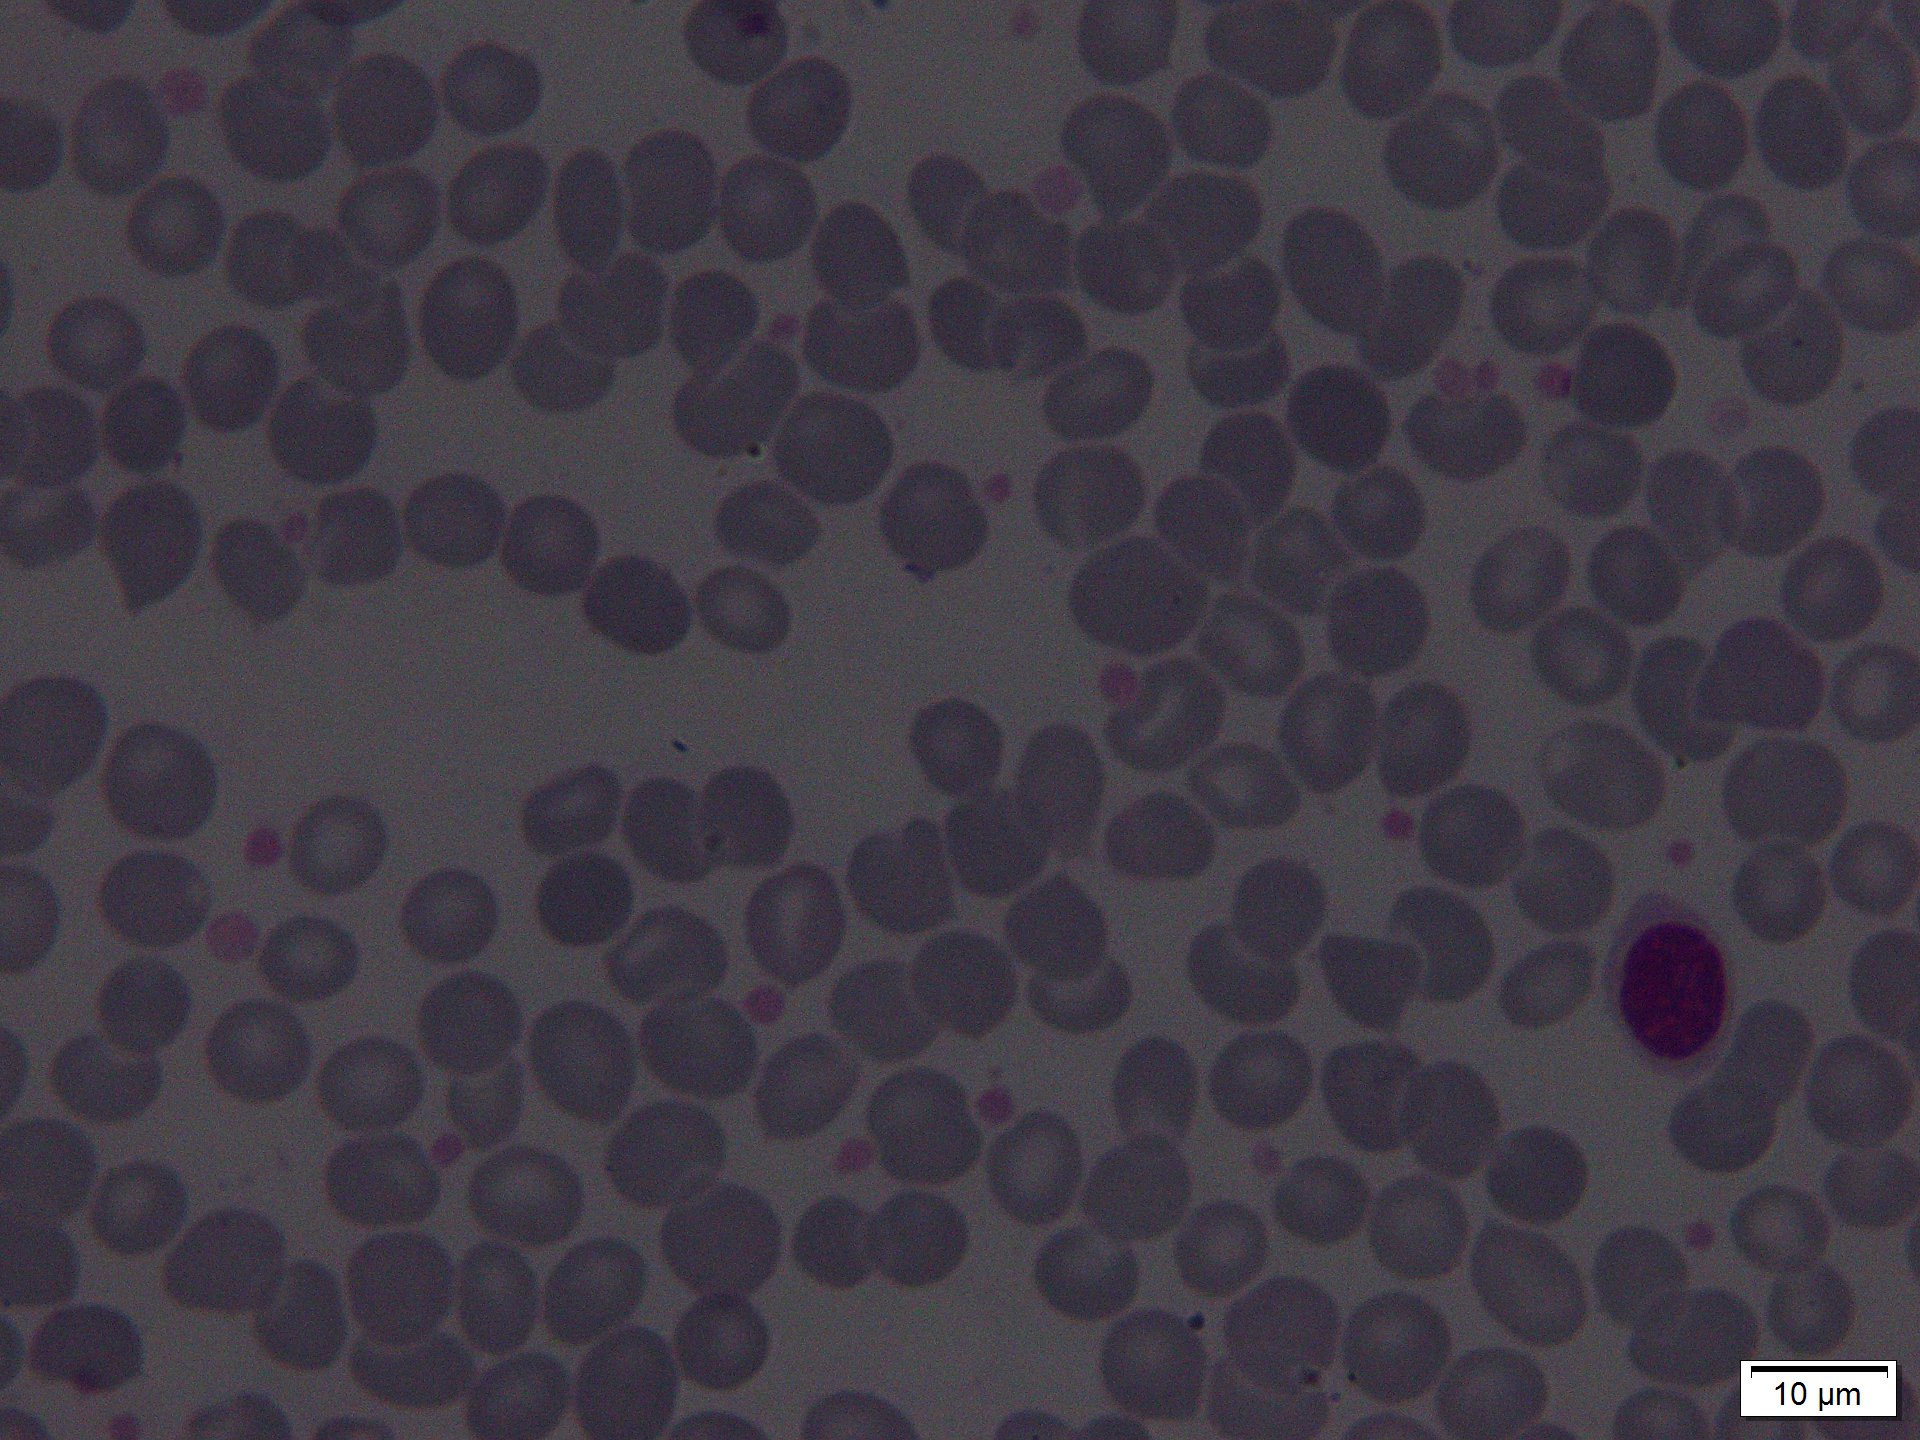
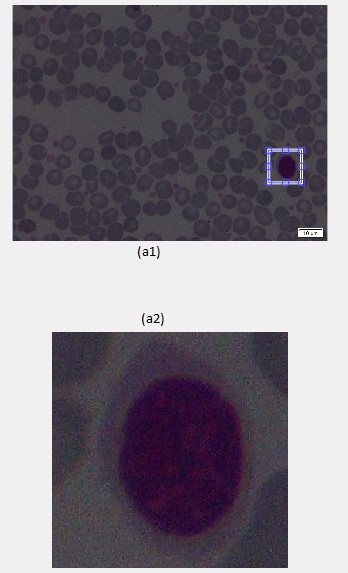

我对如何保存调用错误导致的ROI感到困惑。我想把图像保存在subplot(2,1,2)上
守则是:
function Zoomer
figure();
highResImage = imread('E:\My Work\THESISQ\FIX\Koding\data coba\Image_3060.jpg');
lowResImage = imresize(highResImage,0.5);
a1 = subplot(2,1,1);
a2 = subplot(2,1,2);
imshow(lowResImage,'Parent',a1);
initialPosition = [10 10 100 100];
lowResRect = imrect(a1,initialPosition);
lowResRect.addNewPositionCallback( @(pos)Callback(pos,a2,highResImage));
Callback( initialPosition , a2, highResImage);
end
function Callback(position,axesHandle, highResImage)
position = position * 2;
x1 = position(1);
y1 = position(2);
x2 = position(1) + position(3);
y2 = position(2) + position(4);
highResThumbnail = highResImage( round(y1:y2),round(x1:x2),:);
if isempty( get(axesHandle,'Children'))
imshow(highResThumbnail,'Parent',axesHandle);
else
imHandle = get(axesHandle,'Children');
oldSize = size(get(imHandle,'CData'));
if ~isequal(oldSize, size(highResThumbnail))
imshow(highResThumbnail,'Parent',axesHandle);
else
set( imHandle,'CData', highResThumbnail);
end
end
end这是我的照片,我想用这个代码在这张图片上裁剪淋巴细胞
运行我的代码后,结果是
如何将图像保存在subplot(2,1,2)上
发布于 2016-12-19 23:11:11
编辑:,我一开始读你的问题太快了,看起来你已经知道如何使用imrect的坐标从图像中提取子矩阵了,因为你成功地提取和显示了highResThumbnail。您所缺少的唯一部分是如何将矩阵保存为图像。
使用imwrite将highResThumbnail保存为任何受支持的图像格式
例如
imwrite(highResThumbnail, 'thumb.png');如何使用imrect获取图像的一部分
imrect命令只给出x和y的坐标以及宽度和高度。若要保存所选矩形,请执行以下操作。使用坐标索引到图像矩阵中。然后,您可以使用imwrite保存子矩阵。
A = imread('peppers.png');
figure, imshow(A);
h = imrect;
position = wait(h); %Pause until user double clicks on rectangle
%position contains [x y width height]
startx = position(1);
endx = position(1)+position(3);
starty = position(2);
endy = position(2)+position(4);
%Use the coordinates to grab a submatrix of A
B = A(starty:endy, startx:endx, :);
imwrite(B, 'pepper_rect.png');对于子图,只能在活动子图上选择一个矩形。您可以通过再次调用subplot命令在子图之间切换。
%Plot all my images
figure;
subplot(2,1,1);
imshow('peppers.png');
subplot(2,1,2);
imshow('saturn.png');
%Active image is the most recently plotted
h = imrect;
position = wait(h); %Pause until user double clicks on rectangle
%Call subplot again to activate first image
subplot(2,1,1);
h = imrect;
position = wait(h); %Pause until user double clicks on rectanglehttps://stackoverflow.com/questions/41225411
复制相似问题